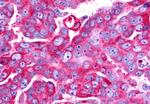
TAAR6 Antibody in Immunohistochemistry (Paraffin) (IHC (P))

Search
Invitrogen
TAAR6 Polyclonal Antibody
{{$productOrderCtrl.translations['antibody.pdp.commerceCard.promotion.promotions']}}
{{$productOrderCtrl.translations['antibody.pdp.commerceCard.promotion.viewpromo']}}
{{$productOrderCtrl.translations['antibody.pdp.commerceCard.promotion.promocode']}}: {{promo.promoCode}} {{promo.promoTitle}} {{promo.promoDescription}}. {{$productOrderCtrl.translations['antibody.pdp.commerceCard.promotion.learnmore']}}
产品信息
PA5-34242
种属反应
宿主/亚型
分类
类型
抗原
偶联物
形式
浓度
规格
纯化类型
保存液
内含物
保存条件
运输条件
RRID
产品详细信息
Percent identity with other species by BLAST analysis: Human, Chimpanzee, Monkey, Marmoset (100%) Rabbit (93%) Bovine, Hamster (86%).
靶标信息
Trace amines are biogenic amines present in very low levels in mammalian tissues. Although some trace amines have clearly defined roles as neurotransmitters in invertebrates, the extent to which they function as true neurotransmitters in vertebrates has remained speculative. Trace amines are likely to be involved in a variety of physiological functions that have yet to be fully understood. Expressed at low abundance in various brain tissues, as well as in fetal liver, but not in the cerebellum or placenta. In the brain, comparable levels of expression in basal ganglia, frontal cortex, substantia nigra, amygdala and hippocampus, highest expression in hippocampus and lowest expression in basal ganglia.
仅用于科研。不用于诊断过程。未经明确授权不得转售。
篇参考文献 (0)
生物信息学
蛋白别名: G-protein coupled receptor; RP11-295F4.3; TaR-4; TaR-6; Trace amine receptor 4; trace amine receptor 6; Trace amine-associated receptor 6
基因别名: TA4; TAAR6; taR-4; taR-6; TAR4; TAR6; TRAR4
UniProt ID: (Human) Q96RI8
Entrez Gene ID: (Human) 319100